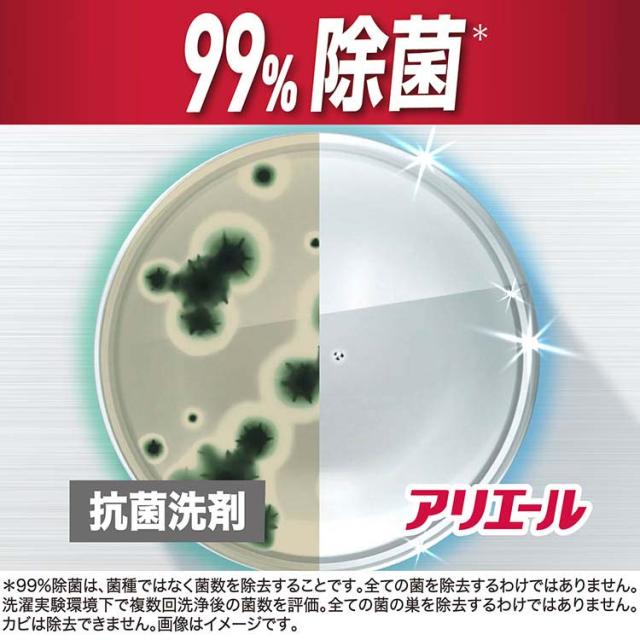

アリエール 洗濯洗剤 液体 洗濯槽まるごと除菌 スッキリひかえめな香り 詰め替え(1000g)[洗濯洗剤 その他]
Pontaパス特典
サンキュー配送
1,347円(税込)
0ポイント(1%)
商品説明

商品に関するお電話でのお問合せは、下記までお願いいたします。
受付時間9:15-17:00(月-金曜日、祝日・年末年始を除く)
衣料用洗剤・柔軟仕上げ剤:0120-021321
食器用洗剤・布製品消臭剤・置き型消臭剤:0120-118226
乳幼児用紙おむつ:0120-021329
ヘアケア製品:0120-021327
マックスファクター化粧品:0120-021325
男性用・女性用グルーミング製品:0120-113937
ブラウン製品(シェーバー、オーラルケア製品、脱毛器)のお問い合わせにつきましては、下記までお願いいたします。
受付時間9:00-17:30(月-金曜日、祝日・年末年始を除く) 0120-136343
リニューアルに伴い、パッケージ・内容等予告なく変更する場合がございます。予めご了承ください。
【ブランド】
アリエール 液体
【発売元、製造元、輸入元又は販売元】
P&G(プロクター&ギャンブル)
【アリエール 洗濯洗剤 液体 洗濯槽まるごと除菌 スッキリひかえめな香り 詰め替えの商品詳細】
●全素材※1洗浄 + スゴ泡処方除菌※2
●お出かけ着も!作業着も※3、体操服も※4 + しつこいニオイも断つ※5
●洗濯槽まるごと除菌※2※6
●黒ずみ防止!つけ置きなしでニオイスゴ落ち※5
●洗濯中、菌を落とす + 洗濯後、菌を増えにくく! W効果!
●18時間超抗菌!※7
●10%濃縮!※8 少ない量で同じだけ洗える
●縦型・ドラム式・すすぎ1回OK
※1 P&G調べ。お出かけ着、体操着、作業着に関して。
※2 全ての菌を除去するわけではありません。
※3 ポリコットンでテスト。
※4 綿100%でテスト。
※5 P&G調べ。ニオイの度合いで消臭の程度は異なります。
※6 洗濯実験環境下で複数回洗浄後の菌数を評価。全ての菌の巣を除去するわけではありません。カビは除去できません。
※7 洗濯実験環境下で複数回洗浄後の菌数を評価。全ての菌の巣を除去するわけではありません。カビは除去できません。
※8 2023年のアリエール超抗菌プレミアムシリーズ比。
●洗濯洗剤
品番:4987176309082
【使用方法】
・重要!自動投入の際は初期設定時に「水30Lあたり27mL」で設定ください。
・使用量の目安:洗濯機/水30Lに27mL(詳しくはボトル記載の使用量の目安をご覧ください。)
・製品に蛍光剤は配合しておりませんが、生産工程上微量に含まれることがあります。
・開ける際にはキャップの切り口と液の飛び出しに気をつけてください。
・洗濯機には洗剤投入口から投入する。
・色柄の衣類に直付け・つけ置きする場合は、目立たない所につけて色落ちしないか事前に確認する。
【成分】
| 界面活性剤(33%:直鎖アルキルベンゼンスルホン酸塩、ポリオキシエチレンアルキルエーテル)、pH調整剤(クエン酸)、安定化剤、分散剤 |
【注意事項】
・背面に記載の注意事項と応急処置をご確認ください。
★危険
・眼に入ると損傷のおそれ。
・酸性タイプ。
・塩素系の製品と一緒に使う(混ぜる)と有害な塩素ガスが出て危険。
・これは飲み物ではありません。
・眼に入ると損傷のおそれ。皮膚刺激のおそれ。
・子供の手の届くところに置かない。
★眼に入った場合
・直ちに15分以上、水でやさしく洗い流し、医師に相談する。
★皮膚についた場合
・石けんと水で洗い流す。
★使用上の注意
・認知症の方などの誤飲を防ぐため、置き場所に注意する。
・用途以外に使用しない。
・眼や皮膚への接触を避ける。
・原液で使う場合や手洗いに用いる場合は炊事用手袋を使う。
・原液が洗濯機についた時は、水ですぐ拭き取る。
・窒息の原因になる可能性がありますので、容器キャップは常に固く締め、お子様が誤って口にいれないようにしてください。
★応急処置
・万一飲み込んだ場合は水を飲ませる。
アリエール 洗濯洗剤 液体 洗濯槽まるごと除菌 スッキリひかえめな香り 詰め替えに関する詳細なお問合せは下記までお願いします
P&G(プロクター&ギャンブル)
651-0088 兵庫県神戸市中央区小野柄通7丁目1番18号 ※お問合せ番号は商品詳細参照
ショップ名 爽快ドラッグ
全素材洗浄+スゴ泡処方除菌
レビュー
商品の評価:



 -点(0件)
-点(0件)









